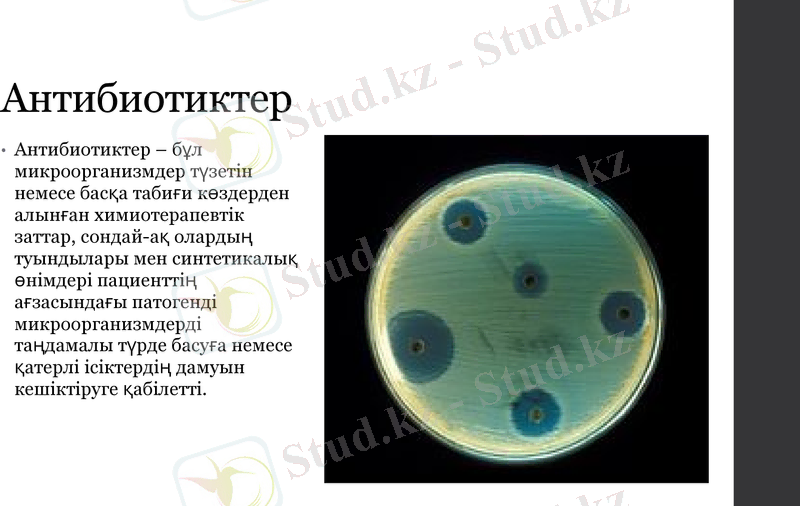
Slide 3

Стрептомицинді өндіру: аминогликозидтердің жіктелуі, тарихы, әсер ету механизмі және өндірістік технологиясы



Стрептомицин өндірісі

Жоспар
Антибиотиктер
Жіктелуі
Аминогликозидтер
Тарихи мәліметтер
Жумыс істеу принцыпы
Стрептомицин
Стрептомицинді өндіру
Стрептомицинді өндірудің аспаптық сұлбасы:
Стрептомицинді өндірудің техникалық сұлбасы:
Антибиотиктер
Антибиотиктер - бұл микроорганизмдер түзетін немесе басқа табиғи көздерден алынған химиотерапевтік заттар, сондай-ақ олардың туындылары мен синтетикалық өнімдері пациенттің ағзасындағы патогенді микроорганизмдерді таңдамалы түрде басуға немесе қатерлі ісіктердің дамуын кешіктіруге қабілетті.

Жіктелуі
Антибиотиктердің алуан түрлілігі және олардың адам ағзасына әсері микробқа қарсы препараттарды жіктеуге және топтарға бөлуге себеп болды. Бактерия жасушасына әсер ету сипаты бойынша антибиотиктерді екі топқа бөлуге болады:
Бактериостатикалық (бактериялар тірі қалады, бірақ көбейе алмайды),
Бактерицидтік (бактериялар өледі, содан кейін денеден шығарылады) .

Жіктелуі
Классификация по химической структуре, которую широко используют в медицинской среде, состоит из следующих групп:
Бета-лактамды антибиотиктер үш топшаға бөлінеді:
Пенициллиндер - Penicillinum саңырауқұлақтарының колониялары өндіреді;
Цефалоспориндер - пенициллиндерге ұқсас құрылымы бар. Пенициллинге төзімді бактерияларға қарсы қолданылады.
Карбапенемдер - құрылымы пенициллиндер мен цефалоспориндерге қарағанда лактамазаларға төзімді, бұл әсер ету спектрін айтарлықтай кеңейтеді.
Монобактамдар - бүгінгі күні топтың жалғыз өкілі - аэробты грамтеріс бактерияларға қарсы селективті әсер ету спектрі бар Aztreonam.

Жіктелуі
Макролидтер - күрделі циклдік құрылымы бар антибиотиктер. Әрекет бактериостатикалық.
Тетрациклиндер тыныс алу және зәр шығару жолдарының инфекцияларын емдеу үшін, күйдіргі, туляремия, бруцеллез сияқты ауыр инфекцияларды емдеу үшін қолданылады. Әрекет бактериостатикалық.
Аминогликозидтер өте уытты. Қан улану немесе перитонит сияқты ауыр инфекцияларды емдеу үшін қолданылады. Әрекет бактерицидтік.
Амфениколдар - қолдану ауыр асқынулардың қаупінің жоғарылауына байланысты шектеулі - қан жасушаларын шығаратын сүйек кемігінің зақымдалуы. Әрекет бактериостатикалық.

Жіктелуі
Гликопептидті антибиотиктер бактерия жасуша қабырғасының синтезін бұзады. Олардың бактерицидтік әсері бар, бірақ энтерококктарға, кейбір стрептококктарға және стафилококктарға қарсы бактериостатикалық әсер етеді.
Линкосамидтердің бактериостатикалық әсері бар, ол рибосомалардың белок синтезін тежеуіне байланысты. Сезімтал микроорганизмдерге қарсы жоғары концентрацияларда бактерицидтік әсер көрсетуі мүмкін.
Фторхинолондар - ципрофлоксацин, норфлоксацин, офлоксацин, пефлоксацин, ломефлоксацин, спарфлоксацин, левофлоксацин, моксифлоксацин, гемифлоксацин, гатифлоксацин, ситафлоксацин, тровафлоксацин, делафлоксацин.
Әртүрлі топтардың антибиотиктері - Рифамицин, Ристомицин сульфаты, Фузидин-натрий, Полимиксин М сульфаты, Полимиксин В сульфаты, Грамицидин, Гелиомицин.
Моноклональды антиденелер - безлотоксумаб.

Аминогликозидтер
Аминогликозидтер - химиялық және биологиялық қасиеттері мен әсер ету механизмі бойынша ұқсас антибиотиктердің үлкен тобы. Олардың құрылымында агликонды (қантсыз) фрагментпен гликозидтік байланыс арқылы байланысқан амин қанттары бар. Олар стрептомициндер және неомициндер болып екіге бөлінеді.
Аминогликозидтер микробқа қарсы белсенділіктің кең спектріне ие, соның ішінде Gr+ және Gr- микроорганизмдердің көпшілігі. Кейбір антибиотиктер Pseudomonas aeruginosa және қарапайымдыларға қарсы белсенді.
Аминогликозидтердің төрт покалениясы бар:
I поколения: стрептомицин канамицин неомицин
II поколения: гентамицин, нетилмицин, тобрамицин, сизомицин
III поколения: амикацин
IV поколения: изепамицин

Тарихи мәліметтер
Тарихта бірінші аминогликозид 1944 жылы Streptomyces griseus актиномицеттерінен бөлініп алынған стрептомицин болды. Бұл жалпы белгілі антибиотиктердің бірі болды, пенициллиннен кейінгі екінші. Канамицин 1957 жылы оқшауланған.
Антибиотикалық терапия дәуірінің басында стрептомицин пенициллинмен бірге кеңінен және дерлік бақылаусыз қолданылды, соның ішінде қазіргі уақытта аминогликозидті антибиотиктерді тағайындау үшін көрсеткіш ретінде қарастырылмаған банальды инфекциялар үшін. Бұл банальды инфекциялар қоздырғыштарының стрептомицинге төзімділігінің артуына және басқа аминогликозидтерге ішінара айқаспалы төзімділіктің пайда болуына ықпал етті.
Кейіннен стрептомицин жоғары ототоксикалық және нефротоксичность, сондай-ақ ең көп таралған қоздырғыштарға төзімділіктің жылдам дамуына байланысты туберкулезге қарсы арнайы химиотерапияның біріктірілген режимдерінің бөлігі ретінде дерлік қолданыла бастады, сонымен қатар кейбір сирек кездесетін, оба сияқты жұқпалы дерлік жойылды, ал канамицин ұзақ уақыт бойы басқа клиникалық жағдайларда қолданылатын негізгі аминогликозид болды.

Жумыс істеу принцыпы
Аминогликозидтер белсенді тасымалдаумен де, пассивті диффузиямен де жасуша қабырғасынан бактерияларға енеді.
Аминогликозид микроб жасушасына енгеннен кейін бактерия рибосомасының 30S суббірлігіндегі рецепторлармен байланысып, оның т-РНҚ-мен әрекеттесуін бұзады.
Нәтижесінде белок синтезінің трансляция сатысында микроорганизмнің полипептидтік тізбектеріне аминқышқылдарының қосылу реттілігі бұзылады.
Дәрілер сонымен қатар микроорганизмнің цитоплазмалық мембранасының қызметі мен құрылымын бұзады, бұл микроб жасушасынан аминқышқылдарының, нуклеотидтердің, калий иондарының қоршаған ортаға шығуына және нәтижесінде оның өлуіне әкеледі.

Стрептомицин
Стрептомициндер - Streptomyces тұқымдасының саңырауқұлақтары шығаратын антибиотиктер.
Стрептомицин және оның туындылары микробқа қарсы белсенділіктің кең спектріне ие. Медицинада стрептомициндердің негізгі қолданылуы туберкулезде, өйткені бұл антибиотиктер туберкулез таяқшасы болып табылатын қышқылға төзімді бактерияларға қарсы микробқа қарсы белсенділік көрсетеді.
Анаэробтар, спирохеттер, риккетсиялар, вирустар, патогенді саңырауқұлақтар, қарапайымдылар стрептомицинге сезімтал емес
Жанама әсерлері мүмкін: дәрілік безгегі, дерматит, дисбактериоз, эозинофилия, сирек - анафилактикалық шок. Стрептомицин әсерінің фонында суперинфекция дамуы мүмкін. Ең ауыры - стрептомициннің ототоксикалық әсері.

Стрептомицинді өндіру
Стрептомицинді алу үшін ауа мицелийлері мен спораларын түзетін Streptomyces griseus актиномицетінің штамдары қолданылады. Продуцент ет сығындысы бар сұйық қоректік ортада стрептомициннің максималды мөлшерін құрайды.
Қоректік орталардың негізі ретінде өсімдік немесе жануар ақуыздарының гидролиз өнімдері қолданылады.

1. 2 - шикізатқа арналған таразылар;
3 - қоректік ортаны дайындауға арналған ыдыс;
4 - себуге арналған аппараттар;
5 - биореактор;
6 - центрифуга;
7 - биомасса сыйымдылығы;
8 - биомасса мен каолинге арналған таразылар;
9 - каолинді зарарсыздандыруға арналған электр кептіру шкафы;
10 - араластырғыш;
11 - гранулятор;
12 - түйіршікті биомассаны каолинмен кептіруге арналған электр кептіру шкафы;
13 - диірмен;
14 - вибрациялық елеуіш;
15 - өнімді стандарттауға арналған ыдыс;
16 - дайын өнімді орау және таңбалау қондырғысы;
17 - дезинфекциялық ерітіндіге арналған ыдыс
Стрептомицинді өндірудің аспаптық сұлбасы:

Қоректік орталардың негізі ретінде өсімдік немесе жануар ақуыздарының гидролиз өнімдері қолданылады. Қоректік орта 120°С-та стерильденеді, салқындатылады және егумен егіледі. Өсіру 25-30 ° C температурада жүзеге асырылады және аэрация және араластырумен бірге жүреді.
- Іс жүргізу
- Автоматтандыру, Техника
- Алғашқы әскери дайындық
- Астрономия
- Ауыл шаруашылығы
- Банк ісі
- Бизнесті бағалау
- Биология
- Бухгалтерлік іс
- Валеология
- Ветеринария
- География
- Геология, Геофизика, Геодезия
- Дін
- Ет, сүт, шарап өнімдері
- Жалпы тарих
- Жер кадастрі, Жылжымайтын мүлік
- Журналистика
- Информатика
- Кеден ісі
- Маркетинг
- Математика, Геометрия
- Медицина
- Мемлекеттік басқару
- Менеджмент
- Мұнай, Газ
- Мұрағат ісі
- Мәдениеттану
- ОБЖ (Основы безопасности жизнедеятельности)
- Педагогика
- Полиграфия
- Психология
- Салық
- Саясаттану
- Сақтандыру
- Сертификаттау, стандарттау
- Социология, Демография
- Спорт
- Статистика
- Тілтану, Филология
- Тарихи тұлғалар
- Тау-кен ісі
- Транспорт
- Туризм
- Физика
- Философия
- Халықаралық қатынастар
- Химия
- Экология, Қоршаған ортаны қорғау
- Экономика
- Экономикалық география
- Электротехника
- Қазақстан тарихы
- Қаржы
- Құрылыс
- Құқық, Криминалистика
- Әдебиет
- Өнер, музыка
- Өнеркәсіп, Өндіріс
Қазақ тілінде жазылған рефераттар, курстық жұмыстар, дипломдық жұмыстар бойынша біздің қор #1 болып табылады.



Ақпарат
Қосымша
Email: info@stud.kz